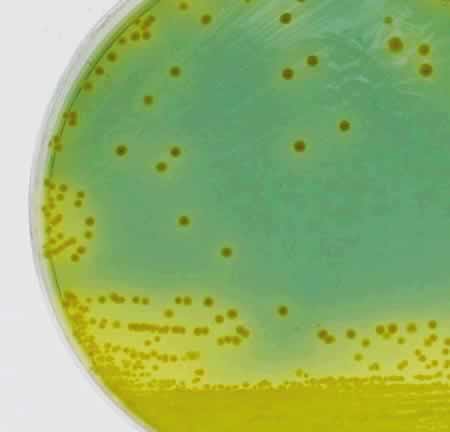
TCBS培地上のナグビブリオの画像

NAGビブリオ感染症
更新作業中のため、ページの一部に古い情報が含まれる場合があります。
(IDWR2001年第12号掲載)
Vibrio choleraeには200以上のO抗原が知られており、ヒトに症状をおこすO1型以外をnonagglutinable vibrios(ナグビブリオ、以下NAG)とよんでいる。NAGの一部はコレラ毒素(CT)を産生するものがあるが大部分は非産生であり、下痢症としても散発的発生がほとんどで、大きな流行はおこさないとされていた。ところが1992年にインド、バングラデシュで脱水症状をおこし、数十人の死者を出したコレラ様下痢症の大きな流行があり、患者からNAGが分離されたが、この菌は今までに分離されていない新血清型のO139であることがわかった。その後の調査でこの菌はCTを産生すること、他の遺伝学的特徴、流行の拡大の速さ、成人にも典型的なコレラ症状を発現させていたことなどから、第二のコレラ菌として扱われ、最初に分離された地名を付してBengal(ベンガル)型コレラ菌ともいわれることになった。

図1.コレラ菌とナグビブリオの鑑別
*コレラ菌の同定は急ぐので分離培地上の集落から直接血清反応を行い、陽性の時は衛生研究所に分離培地を届ける
新しい感染症法の元では、O139CT(+)感染症はコレラとして2類感染症に分類されている。ここで述べるのは、O139を除くNAGについてである。なお毒素を産生しないO1とO139は行政上、NAGと同じく食中毒菌として扱われる(図1)。
疫学
本菌は海水よりも塩分濃度の低い下水や河川水が流入する沿岸汽水域に生息し、水温の上昇する夏季には汚染菌数が多くなる。NAGによる集団発生の報告はあまりみられず、わが国では1978年に長野県の旅館で刺身を原因とするO6による18名の患者発生、1984年高知県での学校給食、冷麺による事例、1985年福岡県の一般家庭料理による9名の事件が報告されている。外国では、1971年にスーダンでCT産生性NAGによる井戸水が原因となった600人以上のコレラ様患者発生の流行、1980年イタリアでの急性胃腸炎の集団発生などをみただけであった。散発下痢症はしばしば発生しており、魚貝類の生食によることが多いが、飲料水汚染がみられるような衛生状態の悪いところでは種々の食品を介しての感染がおこっている。
近年インドやペルーでO10、O11、O12、O54、O144など多くのnon-O1、non-O139血清型菌によるコレラ様下痢症の散発発生や集団発生があり、その病原的研究ではコレラ菌とは全く異なる新しい下痢毒素を産生し、NAGも地域流行の原因となりうることが報告されている。今後海外旅行者下痢症を含めて監視が必要と思われる。
病原体
V.choleraeは一端一毛性のグラム陰性、中等大桿菌で菌体はやや湾曲している(図2)。本菌はわが国における食中毒の主要な原因菌である腸炎ビブリオとは異なり、食塩がない条件でも発育できる。従って、沿岸海水だけではなく日常生活排水が流入する下水、河川水や汚泥からもしばしば検出され、とくに水温が上昇する夏季には高率に分離されることが多い。他の食中毒菌に比べて乾燥、熱、酸に弱いが、NAGはO1よりも抵抗性があり、適当な温度条件では食品中で増殖し、食中毒の原因となることがあるので、食品の低温保存が必要である。

図2.ナグビブリオ(NAG)の走査電子顕微鏡像
図3.TCBS培地上のナグビブリオ(37℃一夜培養集落)
臨床症状
コレラ菌と同じくNAGに汚染された水や食物を経口的に摂取して発生する。喫食後数時間から72時間以内に腹部不快感で始まり、ついで腹痛、悪心、嘔吐、下痢などの症状が現れる。下痢はコレラ類似の水様性から軟便程度までいろいろで、血便や38℃台の発熱をみることがある。
本菌の腸管外感染症としては創傷感染による化膿、心内膜炎、関節炎、髄膜炎のほか、肝硬変や糖尿病患者など免疫力の低下した状態では致命的な菌血症、敗血症に至ることがある。
病原診断
患者由来材料としては下痢糞便が、環境由来材料としては感染源と考えられる食べ残した食品、調理場の拭き取り資料などが検査対象となる。それぞれの検査法はコレラ菌(V.cholerae O1、O139)に順ずる。
糞便は採取後直ちにTCBSなどの選択分離培地に塗抹し、増菌培養も行う。食品は細砕し、1%NaCl加アルカリペプトン水(APW)で増菌した後、分離培養を行う。水、汚泥など環境材料は、濾過が可能なものは濾過し、濾紙をそのままAPWに入れる。泥土など濾過ができないものは、同量の2倍濃度のAPWを加え、37℃で3日間培養するが、毎日分離培養を行う。
NAGはTCBS平板上では、直径2mm程度で平坦な白糖分解性の黄色集落を示すが(図3)、O1やO139コレラ菌とは区別できないので、直接診断用血清によって凝集反応を行い、コレラ菌ではないことを確認する(図1)。集落はTSIなどの確認培地に釣菌し、以後各種の生化学的性状によって同定する。なお、ビブリオ寒天培地上では青色の集落を呈する。
治療・予防
ふつう対症療法のみで約1週間程度で軽快するが、基礎疾患を有する患者や39℃以上の発熱がみられた場合にはテトラサイクリンやニューキノロンなどの抗菌薬投与が必要となる。抗菌薬投与は下痢症状と排菌期間の短縮に有効である。年少者や高齢者などで脱水症状が見られた時には、電解質を含む輸液を積極的に行うよう治療面で考慮する。
予防のためには、患者の多くが魚貝類や飲料水に関連していることから、海産食品の生食とそれからの二次汚染調理済食品、加熱殺菌や消毒をしていない井戸水などの飲用および生野菜の洗浄など、日常生活での使用に注意が必要である。さらに生食用の魚貝類は新鮮なものを購入し、すぐに食べることを心がける。一般的にヒトからヒトへの感染は見られていない。
食品衛生法での取り扱い
食中毒が疑われる場合は、24時間以内に最寄りの保健所に届け出る。
(大阪府立公衆衛生研究所公衆衛生部 小林一寛 河原隆二)

